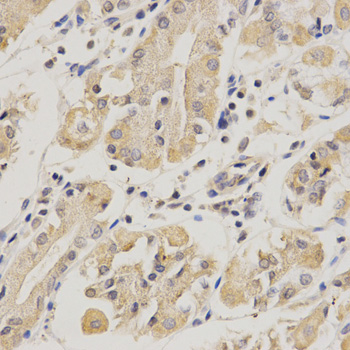
A1673: image 3

For quotations, please use our online quotation form, and you may also contact us by
sales@neoscientific.com
+1-888.733.6849
+1-617.299.7367 (Int’l)
+1-888.733.6849
+1-617.299.7367 (Int’l)
| Reactivity | Human Mouse Rat |
| Tested applications | WB IHC |
| Recommended Dilution | WB 1:500 - 1:2000 IHC 1:50 - 1:200 |
| Calculated MW | 46kDa |
| Observed MW | Refer to Figures |
| Immunogen | Recombinant protein of human SERPINF1 |
| Storage Buffer | Store at -20℃. Avoid freeze / thaw cycles. Buffer: PBS with 0.02% sodium azide, 50% glycerol, pH7.3. |
| Concentration | a |
| Synonym | OI6; OI12; PEDF; EPC-1; PIG35; |

Western blot analysis of extract of various cells, using SERPINF1 antibody.

Immunohistochemistry of paraffin-embedded human esophageal cancer using SERPINF1 antibody at dilution of 1:200 (x400 lens).
Immunohistochemistry of paraffin-embedded human stomach using SERPINF1 antibody at dilution of 1:200 (x400 lens).
Pigment epithelium-derived growth factor (PEDF), also known as EPC-1 (early population doubling level cDNA-1), is a glycoprotein found naturally in the normal eye. PEDF has reported neuroprotective and differentiation properties and is secreted in abundance by retinal pigment epithelium cells. It belongs to the serine protease inhibitor (Serpin) superfamily and has been reported to inhibit angiogenesis and proliferation of several cell types. The “pooling” of PEDF within the interphotoreceptor matrix places this molecule in a prime physical location to affect the underlying neural retina. Additionally, PEDF induces neuronal differentiation and promotes survival of neurons of the central nervous system from degeneration caused by serum withdrawal or glutamate cytotoxicity.
N/A